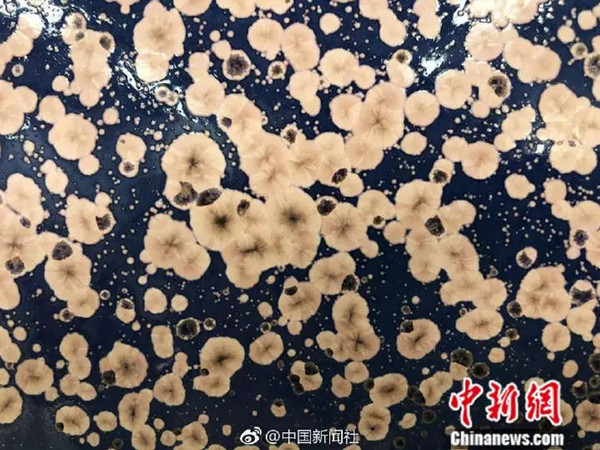

甘肃艺人麦草成飞天神女
文章分类:中国故事 发布时间:2019-03-22
ACTV 阅读( 0 )
麦草竟做成“飞天神女”……甘肃艺人居然有这么多匠心之作


麦草沙石画
碎布头贴画
折纸画
瓷板画
根雕作品
……
小新带你看陇原巧手的匠心作品
↓↓↓
田地里不起眼的麦草竟然能做成“飞天神女”
田地间常见的小麦秸秆、玉米秸秆、砂石子经甘肃多地巧手创作竟然可以变成一幅幅精美的飞天神女、山水人物、花鸟虫鱼的工艺画,这种麦草砂石画既环保又富创意,是劳动妇女智慧的结晶。(记者 徐雪)











田园锦秀、春色撩人、踏青董志塬……一块块碎布头被甘肃陇东的张锐利贴补成不同意境的油画世界。布贴画,原名宫廷补绣,是用各种色彩的布料块、布料条,由缝制者用巧手剪贴而成,作品造型逼真大方,色彩艳而不腻,寓意悠远雅致。(张宏)










绽开的花朵、茂密的森林、矫健的小鹿、憨厚的小象……在兰州折纸艺人马丽亚的工作室内能满足你对童话世界的一切想象。早些年,马丽亚学习了很多技能,但唯独偏爱纸艺。她说,纸本身的可塑性相当高,是极佳的美术创作素材。当一张张纸在自己的设计,绘画,粘贴后呈现出了鲜活生命状态时,那种喜悦感和成就感是无法形容的。(高展)










甘肃民间艺人王清路将粗犷豪放的西北风光融入进瓷板画的创作之中,绘画后的瓷板经过1300℃高温烧制,表面釉色发生自然变化,形成了无法提前预知的奇妙色彩与花纹,如同印象派画家笔下的油画般,带给人无尽的想象空间。(记者 徐雪)

蜜蜂、蚂蚱、蜥蜴、青蛙……在他手下,木头、树根都变能“化腐朽为神奇”,变成不可思议的艺术品。甘肃省平凉市崇信县根雕艺人甘博从事根雕艺术创作20余年,他将身边的一草一木、一花一物以根雕的形式表现出来,气韵生动,让人赏心悦目。(钟欣)










来源:综合中国新闻社微博

(ACTV责任编辑:秦英)
澳大利亚澳华电视传媒 AUS-CHINA TV MEDIA



